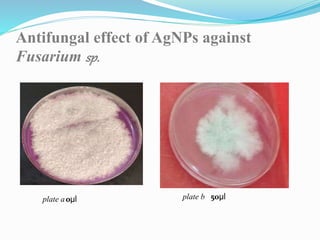
0µl 50µl
Antifungal effect of AgNPs against
Fusarium sp.
plate a plate b
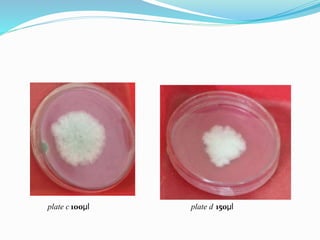
100µl 150µl
plate c plate d

The document summarizes a study analyzing the antifungal activity of silver nanoparticles synthesized by bacteria against Fusarium sp., a fungus that causes guava wilt. The objectives were to isolate Fusarium sp. from infected guava leaves, screen bacteria for silver nanoparticle production, synthesize nanoparticles from a potent bacteria, and test their antifungal activity against Fusarium sp. The results showed that the silver nanoparticles inhibited fungal growth in a concentration-dependent manner, with no growth observed at a concentration of 200 μl of nanoparticles.